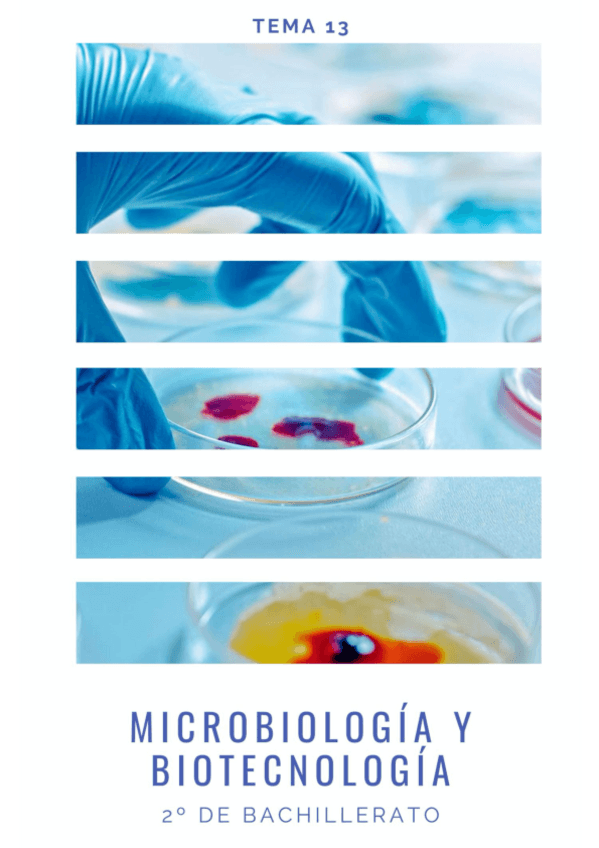

TEMA-1-BIOLOGIA.pdf
12 páginas

TEMA-2-GLUCIDOS.pdf
14 páginas

TEMA-3-LIPIDOS.pdf
10 páginas

TEMA-4-PROTEINAS.pdf
11 páginas

TEMA-5-ENZIMAS-Y-VITAMINAS.pdf
10 páginas

TEMA-6-ACIDOS-NUCLEICOS.pdf
8 páginas

TEMA-7-CITOLOGIA-PARTE-I.pdf
12 páginas

TEMA-7-CITOLOGIA-PARTE-II.pdf
30 páginas

TEMA-8-TEORIA-CELULAR.-TIPOS-DE-ORGANIZACION-CELULAR.pdf
12 páginas

TEMA-9-EL-CICLO-CELULAR.pdf
12 páginas

TEMA-10-CATABOLISMO.pdf
10 páginas

TEMA-10-ANABOLISMO.pdf
7 páginas

TEMA-11-GENETICA-MOLECULAR.pdf
9 páginas

TEMA-11-GENETICA-MOLECULAR-DIFERENCIAS.pdf
3 páginas

TEMA-12-GENETICA-MENDELIANA.pdf
16 páginas
TEMA-13-MICROBIOLOGIA-Y-BIOTECNOLOGIA.pdf
16 páginas

TEMA-14-INMUNOLOGIA.pdf
25 páginas
content_copy